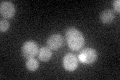
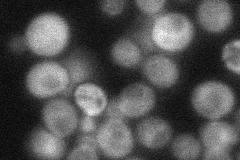
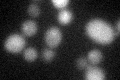

View description
tRNA methyltransferase, catalyzes esterification of modified uridine nucleotides in tRNA(Arg3) and tRNA(Glu), likely as part of a complex with Trm112p; deletion confers resistance to zymocin
Localization:
Intensity:
Fold change:
Significance:
-
C’ GFP library in SD
cytosol27.74 -
N' NOP1pr-GFP in SD

below threshold0 -
N' TEF2pr-mCherry in SD

cytosol132.507 -
N' NATIVEpr-GFP in SD
cytosol46.2049 -
N' TEF2pr-VC and Cyto-VN in SD

#N/A0 -
C’ GFP library in SD+DTT
cytosol23.540.84No -
C’ GFP library in SD+H2O2

cytosol26.470.95No -
C’ GFP library in Starvation Media

cytosol21.250.76No -
C’ GFP library on the background of Pup2-DaMP

cytosol -
C’ GFP library on the background of CCT mutant

cytosol25.18230.907485No
